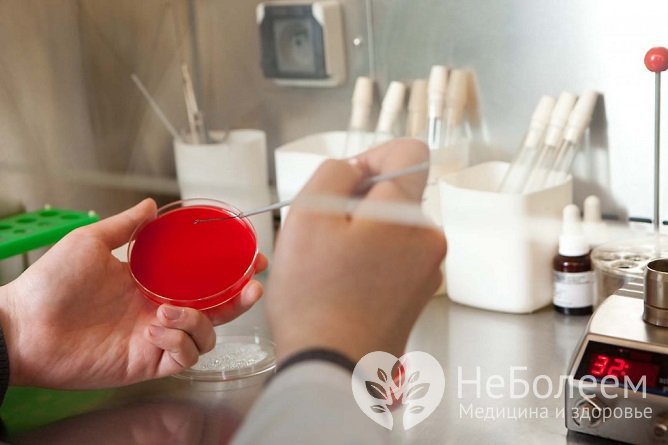

Воспользуйтесь поиском по сайту:
Как лечить пневмонию в домашних условиях у взрослых и детей
Содержание статьи:
Лечение пневмонии в домашних условиях может проводиться только при легком течении патологии по согласованию с врачом. В большинстве случаев воспаление легких требует госпитализации пациента, так как терапия под постоянным медицинским наблюдением является более безопасной и эффективной.
 Лечение пневмонии в домашних условиях должно проводиться только под врачебным наблюдением
Лечение пневмонии в домашних условиях должно проводиться только под врачебным наблюдениемСледует учитывать, что возможно течение патологии без повышения температуры и тяжелого кашля. Поэтому при появлении даже неярко выраженных симптомов рекомендуется обращаться за помощью к врачу, который сможет правильно диагностировать имеющиеся признаки и назначить нужный метод лечения.
При своевременном начале терапии прогноз пневмонии благоприятный, тогда как ее отсутствие или самостоятельный подбор способа лечения чреваты развитием необратимых осложнений, не исключен летальный исход.
Причины развития патологии
Развитию заболевания способствует инфекция в легких, поражающая преимущественно альвеолы и интерстициальную ткань, а не дыхательные пути. Патологию могут вызывать патогенные микроорганизмы, которые попадают в ткани легких с мельчайшими каплями воды, находящимися во вдыхаемом воздухе, через кровеносную систему либо из очагов иных воспалений в организме. К числу возбудителей заболевания относятся:
- бактерии – стрептококк, моракселла, стафилококк, гемофильная палочка, пневмококк;
- простейшие;
- вирусы – риновирусы, грипп;
- хламидии;
- грибки – пневмоциста, кандида;
- риккетсии.
 Пневмококки – частые возбудители пневмонии
Пневмококки – частые возбудители пневмонииВ преобладающем числе случаев воспаление развивается под действием бактериальных агентов. Патогены попадают в воздух от инфицированного человека посредством кашля или чихания. Крайне редко фиксируется неинфекционная форма болезни, появление которой провоцирует длительное вдыхание токсических веществ и ядов.
Триггерные факторы
Вероятность появления пневмонии возрастает при наличии следующих состояний или заболеваний:
- хронические болезни почек, сердца, печени, легких и иных органов;
- онкологические патологии;
- ослабление иммунной системы;
- дефекты грудной клетки (врожденные или приобретенные);
- табакокурение;
- иммунодефицит;
- пребывание на аппарате искусственной вентиляции легких в течение длительного периода;
- вынужденное продолжительное пребывание в положении лежа;
- младенческий и старческий возраст (старше 60 лет);
- перенесенная трансплантация органов;
- сахарный диабет;
- бронхит.
Симптомы воспаления легких
Проявления болезни отличаются в зависимости от степени поражения легкого и типа возбудителя. Характерными для всех пневмоний признаками являются такие, как:
- резкое увеличение температуры тела до 38–40 °C;
- сухой кашель, который со временем становится влажным с вязкой, трудноотделяемой мокротой;
- болезненные ощущения в мышцах;
- гипергидроз;
- озноб;
- головная боль;
- повышенная утомляемость;
- снижение или отсутствие аппетита;
- слабость;
- боль в грудной клетке, которая появляется или усиливается при кашле либо дыхании.
Диагностика заболевания
Для подтверждения диагноза врач собирает анамнез, проводит осмотр пациента и фиксирует его жалобы. После этого больной получает направление на развернутый анализ крови.
Анализ крови
Скорость оседания эритроцитов при воспалении легких всегда превышает нормальные показатели. Умеренный лейкоцитоз и сдвиг лейкоцитарной формулы влево характерны для легкого течения патологии, тогда как выраженное увеличение числа лейкоцитов свидетельствует о воспалительном процессе средней тяжести.
При пневмонии тяжелого течения уровень лейкоцитоза высокий, лейкоцитарная формула резко сдвинута влево вплоть до миелоцитов, а скорость оседания эритроцитов значительно превышает нормальные показатели.
В крови также может определяться анемия, отражающая длительную интоксикацию организма.
Рентгенологическое исследование легких
Наряду с анализом крови, к числу необходимых диагностических мероприятий относится рентгенологическое исследование легких, которое показывает, имеются ли изменения в легочном рисунке.
 Рентген легких имеет важное диагностическое значение
Рентген легких имеет важное диагностическое значениеУ пациентов с пневмонией могут визуализироваться четкие множественные очаги затемнения, усиленная растяженность, берущая начало от расширенной тени корня легкого, или густой сетчатый рисунок с мелкими просветами.
Другие методы диагностики
Особое значение для подбора эффективных методов лечения имеет идентификация возбудителя, а в случаях бактериального заражения – определение чувствительности патогенных агентов к препаратам с антибактериальным действием. С этой целью проводят микроскопическое исследование мокроты, бронхиальных смывов и трахеобронхиального аспирата, а также бактериальный посев.
Для идентификации возбудителя проводится бактериальный посев
Для идентификации возбудителя проводится бактериальный посевВ случаях, когда причину воспаления с применением таких исследований выявить не удается, пульмонолог может назначать биопсию. В ходе ее проведения посредством эндоскопа осуществляется забор зараженного материала из легкого.
Оценка тяжести пневмонии
Оценка тяжести течения патологии является важным критерием для определения возможности проводить лечение дома.
|
Основные признаки |
Легкая степень |
Средняя степень |
Тяжелая степень |
|
Температура |
До 38 °С |
38–39 °С |
Выше 39 °С |
|
Интоксикация |
Отсутствует или выражена несильно |
Умеренно выражена |
Резко выражена |
|
Наличие и характер осложнений |
Обычно отсутствуют |
Развиваются нечасто |
Встречаются часто (в виде эмпиемы, абсцедирования и др.) |
|
Переносимость и эффективность лечения |
Хорошая переносимость, быстрый эффект |
Возможны аллергические и токсические реакции |
Более поздний эффект, частые побочные реакции |
Читайте также:5 способов снизить температуру без лекарств
Лечение воспаления легких в домашних условиях
Терапия патологии в первую очередь должна быть нацелена на уничтожение спровоцировавшей ее развитие патогенной флоры, а не на купирование симптомов. Больному прописывают антибиотики, при их регулярном приеме в рассчитанных врачом дозах проявления болезни проходят в течение нескольких суток, а полное уничтожение инфекции происходит через 1–2 недели.
Наиболее эффективными при воспалении легких лекарствами с антибактериальным действием являются Амоксиклав, Ампициллин, Амоксициллин, Эритромицин, Кларитромицин, Азитромицин, Офлоксацин, Гентамицин, Амикацин.
Важное значение имеет прохождение пациентом полного курса антибиотикотерапии, даже при улучшении состояния уже через несколько дней от ее начала. Ранняя отмена чревата рецидивом и развитием бактериальной резистентности, при которой повторный курс приема препаратов окажется бесполезным.
При пневмониях, вызванных внутриклеточными возбудителями или вирусами, назначают противовоспалительные и противовирусные лекарственные средства. К их числу относятся такие лекарства, как Занамивир, Арбидол и Осельтамивир.
У пациентов с грибковой формой заболевания требуется специфический подход к лечению, поскольку чаще всего такой вид воспаления легких возникает на фоне иммунодефицита. Врач прописывает комбинацию противогрибковых средств с иммуноукрепляющими препаратами.
В качестве симптоматической терапии могут использоваться отхаркивающие, жаропонижающие, противокашлевые или болеутоляющие средства (к примеру, Бромгексин, АЦЦ).
 Массаж часто используется в качестве дополнительного метода лечения
Массаж часто используется в качестве дополнительного метода леченияВ дополнение к консервативным методам могут рекомендоваться способствующие процессу выздоровления мероприятия – лечебная физкультура, массаж и физиологические процедуры.
Общие рекомендации по организации лечении дома
Лечение в домашних условиях может проводиться при условии, что до момента воспаления пациент не страдал тяжелыми инфекционными патологиями, а само течение пневмонии характеризуется как легкое. Важно принимать назначенные пульмонологом лекарства в соответствии с прописанной им схемой, не превышая указанных дозировок.
 В период острого течения болезни важно соблюдать постельный режим
В период острого течения болезни важно соблюдать постельный режимСтоит отметить, что лечение воспаления легких на дому, особенно если болен ребенок, предполагает соблюдение постельного режима и щадящего рациона питания. Рекомендуется обильный прием теплого питья и, при наличии аппетита, употребление мягких неострых пюреобразных блюд.
Терапия при беременности
Если пневмония бактериальной природы диагностируется при беременности, лечение должно проводиться строго под медицинским наблюдением.
Поскольку в этот период допустим прием далеко не всех лекарственных средств, исходя из срока беременности и особенностей ее течения, пациенткам назначают легкие антибактериальные лекарства. Это могут быть препараты с короткой продолжительностью приема или альтернативная им фитотерапия.
Оценка эффективности лечения пневмонии в домашних условиях
Действенность применяемых лекарств можно определить по стиханию симптомов патологии, а именно:
- температура тела снижается и не превышает отметки в 37,5 °С;
- отсутствие признаков интоксикации;
- гнойная мокрота постепенно отходит и перестает выделяться с кашлем;
- проявления, свидетельствующие о дыхательной недостаточности, отсутствуют;
- положительная динамика по данным рентгенологического исследования легких.
Средства народной медицины от пневмонии
В дополнение к консервативному лечению пневмонии в домашних условиях, по рекомендации доктора могут использоваться средства народной медицины. Наиболее эффективными из них считаются такие рецепты, как:
- рецепт №1: в небольшую емкость высыпают 2 ст. ложки овса и такое же количество изюма, заливают 1 л воды и ставят на медленный огонь. Жидкость варят до тех пор, пока ее первоначальный объем не уменьшится в 2 раза. После этого смесь тщательно процеживают, слегка остужают и добавляют в нее 1 ст. ложку меда. В готовом виде средство принимают по 1 ст. ложке 4 раза в сутки на протяжении всего периода медикаментозной терапии;
- рецепт №2: в емкость помещают 1 ст. ложку высушенных ягод малины, травы мать-и-мачехи и душицы, тщательно смешивают. Затем 1 ст. ложку полученного сбора высыпают в термос и заливают 300 мл кипятка. Жидкость настаивают на протяжении 45–60 мин, после чего процеживают. Готовый отвар принимают внутрь небольшими порциями в течение дня;
- рецепт №3: 1 ст. ложку сока алоэ смешивают с 2 ст. ложками медами и заливают 3 ст. ложками водки. Средство перемешивают и заворачивают в марлю. Готовый компресс кладут на область грудной клетки ежедневно перед сном;
- рецепт №4: 40 г очищенных лесных орехов заливают 500 мл красного сухого вина, ставят на медленный огонь и томят на протяжении 20 мин. Лекарство принимают перорально по 1 ст. ложке перед каждым приемом пищи;
- рецепт №5: 100 г высушенных плодов калины обыкновенной заливают 1 л кипятка, ставят на слабый огонь и в течение 10 мин варят. Затем отвар процеживают, немного остужают и добавляют в него 3 ст. ложки меда. Средство пьют в теплом виде по половине стакана 3 раза в день.
Следует учитывать, что домашние лекарства должны применяться не в качестве основного лечения, а как вспомогательная терапия к препаратам первой линии.
Когда показана госпитализация
Сопутствующие хронические заболевания – сахарный диабет, хроническая обструктивная болезнь легких, застойная сердечная недостаточность, хронические нефриты и гепатиты, токсикомания или алкоголизм, иммунодефициты – являются факторами риска развития осложнений. В таких случаях рекомендуется проводить лечение в условиях стационара.
 При наличии факторов риска проводить лечение дома нельзя, и пациенту требуется госпитализация
При наличии факторов риска проводить лечение дома нельзя, и пациенту требуется госпитализацияТакже госпитализация показана при наличии следующих факторов:
- неэффективное амбулаторное лечение в течение трех дней;
- спутанность/снижение сознания;
- число дыханий более 30 в минуту;
- нестабильная гемодинамика;
- инфекционные метастазы;
- септический шок;
- многодолевое поражение;
- абсцедирование;
- экссудативный плеврит;
- лейкопения или лейкоцитоз;
- почечная недостаточность;
- анемия;
- социальные показания;
- возраст от 70 лет.
Видео
Предлагаем к просмотру видеоролик по теме статьи.
Об авторе

Нашли ошибку в тексте? Выделите ее и нажмите Ctrl + Enter.
Кроме людей, от простатита страдает всего одно живое существо на планете Земля – собаки. Вот уж действительно наши самые верные друзья.
























